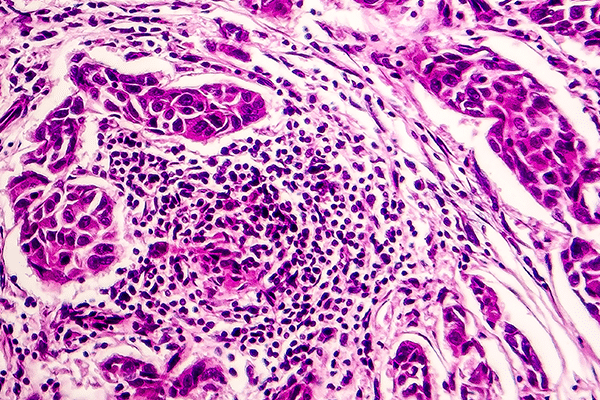
Le système lymphatique

Huile, baume ou crème : quel est l’allié idéal de la technique Kyokutē ?
La pratique du Kyokutē ne se limite pas à une succession de gestes techniques. C’est une véritable immersion dans la biologie cutanée où chaque pression et chaque étirement visent la régénération profonde. Pour que ce dialogue avec les tissus soit efficace, le choix du support cosmétique devient une décision stratégique. En effet, un produit mal…